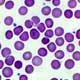
Healing Wounds With Freeze-dried Blood Platelets
Healing Wounds With Freeze-dried Blood Platelets

Researchers say that ointments and bandages infused with essence of maggot could help speed up wound healing.
Researchers say that ointments and bandages infused with essence of maggot could help speed up wound healing.
Hundreds of years ago battlefield medics noticed that bloody wounds infested with maggots actually heal faster than "clean" wounds.In today's time, worldwide hospitals breed selected fly larvae in sterile environments. The "medical maggots" are applied directly to wounds such as ulcers and burns, which are otherwise difficult to heal.
However, the healing process of maggot therapy has long been a matter of debate.
Now, a new study suggests, the secret lies in a fluid secreted by the maggots to help them consume decaying tissue.
In many wounds that are not readily healing, tissue decays and dies, allowing bacteria to thrive. This creates irritation that further prevents proper healing.
"We have produced an enzyme from the maggot fluid with the capacity to remove decaying tissue from the wound, giving the underlying tissue a better chance to heal," National Geographic News quoted David Pritchard, a researcher working on the project at the University of Nottingham School of Pharmacy in the U.K, as saying.
Source-ANI
ARU
MEDINDIA

Email





